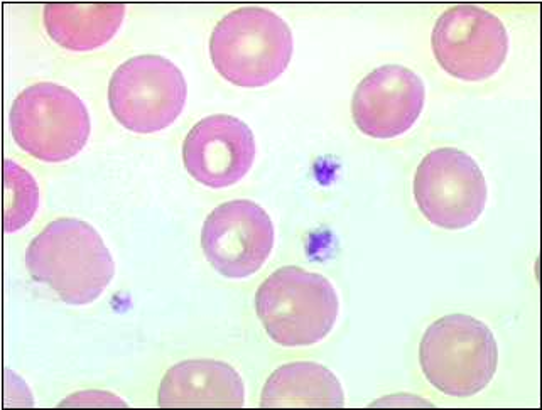
/images/2-bloedsomloop/morfologie/1.11s.png

Fig 1.01: plasma vs serum
5min centriguren aan 10 000G zonder vs met anticoagulantia -
bloed
5-6l 8% BW -> 75 ml/kg -
plasma (55-60%, 4% BW)
-
cellen (40-45%)
-
erythrocyten = rode bloedcellen (RBC)
-
leukocyten = witte bloedcellen (WBC)
12-15 um -
granulocyten
neutrofielen eosinofielen basofielen
lymfocyten monocyten
-
thrombocyten = bloedplaatjes (BP)
buffy coat = leukocyten + thrombocyten -
hematocriet = %RBC = RBC / T
serum = H2O + albumine + antilichamen + andere eiwitten plasma = serum + fibrinogeen + stollingsfactoren
|
N/A |
 Fig 1.02: schematische opbouw van beenmerg
bot (trabekels) sinusoiden = capillairen met endotheelcellen (groen) -
adipocyten = vetcellen (oranje)
macrofagen -
hematopoietische cellen (zie 1.03)
-
erythrocytaire erythroblasten
myeloblast > granulocyten megakaryocyt > thrombocyten
|
 
|
 Fig 1.03: hematopoiese of bloedcelvorming
|
 |
 Fig 1.04: ligging van de milt
|
 |
 Fig 1.05: macroscopische opbouw van de milt
|
 |
 Fig 1.06: opbouw van de circulatie van de milt
-
parenchym = miltpulpa
-
rode pulpa (75%)
reticulair bindweefsel veneuze sinussen balkjes van Billroth
-
witte pulpa (25%)
-
centrale arterie
|
 |
 Fig 1.07: histologische opbouw van de milt
|
N/A |
 Fig 1.08: microscopisch uitzicht van de erythrocyt
-
hemoglobine (Hb)
-
biconcaaf
geen organellen: kern, mitochondria, ER, ribosomen leven 120 dagen \(2.5 \times 10^11\) per dag = 0.8% per dag -
bloedgroep antigenen
ABO: A/B/AB/O rhesusfactor (Rh): +/-
stilstaand -> rouleaux
|
N/A |
 Fig 1.09: erythrocyt - evolutie volgens rijpingsgraad
-
erythropoese
hematopoietische stamcel (HSC, 10 um) myeloide voorlopercel = progenitor pro-erythroblast basofiele erythroblast polychromatofiele erythroblast (laatste die nog kan delen) normoblast (geen deling wegens kernpycnose) reticulocyt erythrocyt (7-9 um)
x-as: tijd (tot 7 dagen) -
y-as
ribosomen (basofiel wegens RNA, groen) Hb (acidofiel wegens basisch eiwit, rood)
|
 |
 Fig 1.10: de reticulocyt
|
 |
 Fig 1.11: de rijpe thrombocyt - microscopie
kernloos 2 - 5 um -
7 - 10 dagen
granulomeer (paars, centraal) hyalomeer (zachtblauw, perifeer)
|
 |
 Fig 1.12: de thrombocyt - ultrastructuur
geen kern mitochondria Golgi complex + RER (geel) glycogeenkorrels (rood) peroxisomen -
granulen
lysosomen -
glycocalyx (negatief geladen, adhesie)
tubuli (cyaan) microtubuli (actine, myosine, vormverandering, perifeer) adhesie vs aggregatie vs coagulatie pseudopodia na activatie
|
 
|
 Fig 1.13: de megakaryoblast
|
 |
 Fig 1.14: de megakaryocyt
90-150 um in beenmerg, niet in bloed grillige vorm gelobde kern cytoplasma: minder basofiel, azurofiele korrels granules (alfa, dense) mitochondria Golgi RER -
demarcatiemembranen > prospectieve plaatjesvelden > thrombocyten
|
 |
 Fig 1.15: vorming van demarcatiemembranen
prothrombocyten thrombocyten -
kern
|
 |
 Fig 1.16: overzicht van de componenten van hemostase
|
 
|
 Fig 1.17: de verschillende stappen in de aggregatie, primaire hemostase
A inactieve thrombocyt (BP)
gezond endotheel (blauw) -
thrombocyt (groen)
laag Ca2+ GP IIb/IIIa receptor
-
inhiberende factoren
-
glycocalyx
op endotheel en thrombocyt negatief geladen -> afstoting -
prostaglandines: prostacycline
ADP-ase
B actieve thrombocyt (aBP = BPa)
|
 |
 Fig 1.18: stollingssysteem
A intrinsieke pathway
-
XII -> XIIa
-
IIa = thrombine
-
VIIIa + IXa + Ca2+
merk op: VIII, IX, X, XI, XII
B extrinstieke pathway
-
III = TF
-
TF + VIIa + Ca2+
trimoleculair complex X -> Xa
merk op: III + VII = X
C common pathway
|
 |